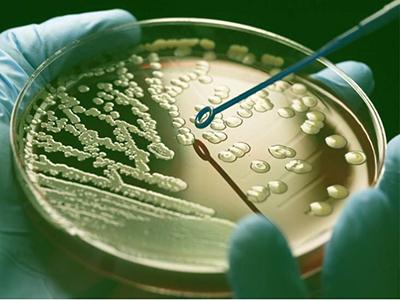

The specificity of antibodies and their affinity to a target is primarily based on selecting the best antigen within the target. If this step is wrongly done, the entire development will be wasted. This is why we take our time to get the antigen selection step right and to make sure the antibodies we develop are very specific to their target.

We use a combination of readily available tools for antigen selection.
Isoform sequence information is used to ensure the antigen is present in the canonical sequence as well as all or most other isoforms. Some projects would like us to develop antibodies against specific isoforms, and that we can do too!
BLAST tools are used to ensure that the antigen we select is also reactive with mouse. In cases where cross-reactivity is difficult to achieve, we would develop antibodies to both human and mouse and combine the two in the final vial. For target requests other than human/mouse species, we would prioritise the antigens for that species instead.
BLAST tools are also used to make sure the antigen is unique to the target and not present in family members or related genes. This allows the development of very specific antibodies.
We look at the 3D confirmation of the protein to increase the success of our antibodies working in applications that do not denature the target.
The antigens that combine the best of the above points are selected for antibody development.
We use several Display Technologies in our laboratories to ensure that there is no protein target or application out of reach.
Display technologies link the antibody binding activity (Phenotype) to the DNA that encodes for the antibody (genotype). This allows the selection and identification of desired antibodies from libraries that range in the billions of different antibodies.

For each type of Display Technology, we have constructed libraries from different species. With this large and varied starting point of naïve antibodies, we are able to select a preliminary medium affinity antibody to any target antigen. These modest affinity antibodies make the backbone of the next steps in the antibody development process.
The DNA from the selected antibodies above are extracted, purified and pooled into a new DNA library. This DNA library undergoes gradient mutagenesis, where different levels of mutations are introduced. We use both random mutagenesis and site directed mutagenesis to achieve this.
In the random mutagenesis process, a low fidelity polymerase is used in a buffer that reduces the polymerase fidelity further. The composition of the buffer can control the level of fidelity of the polymerase, and by amplifying the DNA a gradient of random mutations can be achieved.
In the site-directed mutagenesis process, random mutations are introduced computationally in primers spanning the entire antibody binding region. These primers are used to amplify different part of the DNA, which are then joined up in a final over-lap extension PCR step.

The DNA from both the above processes are used to make a new antibody library that will be used to select higher affinity antibodies.
This process is repeated until a few antibody clones can recognize their target at endogenous levels.
Successful antibody clones coming out of the Affinity Maturation stage are finally cloned into our proprietary expression systems and pooled together to make a final multi-clonal antibody. This enters our state-of-the-art manufacturing facilities that ensures the production in a consistent and reproducible way.